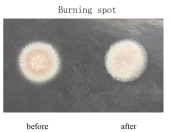
High Precision Cell Mirror for Nd:YAG Q-Switch Laser photo 3

Description
CRYSTECH brings you the Cell Mirror, a cutting-edge optical component specifically designed for Nd:YAG Q-Switch Laser Medical Devices. With over a decade of experience in the manufacturing, design, and coating of cell mirrors, CRYSTECH ensures precision and reliability in every product. The Cell Mirror is a binary optical element that plays a crucial role in transforming the Gaussian beam within laser systems into a flat-topped beam, optimizing the performance and efficiency of the laser device.
Our expertise in cell mirror technology allows us to provide solutions for various Q-Switch systems, including those operating at 1064nm, 755nm, and 694nm wavelengths. The transformation of the beam spot before and after homogenization is a testament to the quality and effectiveness of our Cell Mirror technology. This transformation is critical for applications requiring uniform beam profiles, enhancing the overall output quality of laser systems.
Our commitment to innovation and quality assurance is evident in the meticulous design and manufacturing processes employed for the Cell Mirror. Each product undergoes rigorous testing to ensure it meets the high standards demanded by the laser and medical industries. By choosing CRYSTECH's Cell Mirror, you are investing in a product that delivers precision, reliability, and superior performance.
High Precision Cell Mirror for Nd:YAG Q-Switch Laser
Specifications
| Substrate Material: | BK7, Metallic, IR Fused Silica, UV Fused Silica, Fused Silica |
|---|---|
| Wavelength Range: | 1064 – 1064 nm |
| Flatness (Coated Surface): | lambda/10 |
| Surface Quality: | 20-10 scratch-dig |
| Diameter: | 15 mm |
| Thickness: | 4 mm |
| Wavelength: | 755 nm |
| Wavelength: | 694 nm |
| Size: | φ15X4 |
| Size: | φ20X4 |
| Size: | φ25.4X4 |
| Curvature: | R=-2500 |
| Curvature: | R=-3000 |
| Curvature: | R=-4000 |
| Curvature: | R=-2000 |
| Wavelength: | 1065 nm |
| Wavelength: | 1064 nm |
Got questions about specs? Use the inquiry form to ask.
Features
- High Precision Manufacturing: CRYSTECH is dedicated to producing high precision Cell Mirrors for Nd:YAG Q-Switch Laser Medical Devices, ensuring top-quality performance and reliability.
- Over a Decade of Experience: With more than 10 years of expertise in cell mirror manufacturing, design, and coating, CRYSTECH guarantees superior quality and innovation.
- Beam Transformation: The CellMirror is a binary optical element that transforms the Gaussian beam in laser systems into a flat-topped beam, enhancing the efficiency and effectiveness of laser applications.
- Wavelength Compatibility: CRYSTECH provides Cell Mirrors compatible with 1064nm, 755nm, and 694nm Q-Switch systems, catering to a wide range of laser applications.
- Beam Quality Analysis: The product ensures improved beam quality, as evidenced by the beam spot before and after homogenization, providing consistent and reliable performance.
- Variety of Standard Products: CRYSTECH offers a range of standard products with different sizes, coatings, and curvatures to suit specific needs:
- P/N: OP.CLM.D15004.C002, Size: φ15X4, Coating: 1064nm, Curvature: R=-2500
- P/N: OP.CLM.D15004.C003, Size: φ15X4, Coating: 1064nm, Curvature: R=-3000
- P/N: OP.CLM.D15004.C004, Size: φ15X4, Coating: 1064nm, Curvature: R=-4000
- P/N: OP.CLM.D15004.C005, Size: φ15X4, Coating: 1064nm, Curvature: R=-2000
- P/N: OP.CLM.D20004.C002, Size: φ20X4, Coating: 1064nm, Curvature: R=-2500
- P/N: OP.CLM.D20004.C020, Size: φ20X4, Coating: 1064nm, Curvature: R=-4000
- P/N: OP.CLM.D25004.C001, Size: φ25.4X4, Coating: 1064nm, Curvature: R=-2000
- P/N: OP.CLM.D25004.C002, Size: φ25.4X4, Coating: 1065nm, Curvature: R=-4000
Applications
- Precision Cell Mirror Manufacturing: CRYSTECH specializes in high precision Cell Mirrors for Nd:YAG Q-Switch Laser Medical Devices.
- Gaussian Beam Transformation: Our Cell Mirrors are binary optical elements designed to transform the Gaussian beam in laser systems into a flat-topped beam, enhancing laser performance.
Frequently Asked Questions
What is the CellMirror used for?
What wavelengths can the CellMirror handle?
What sizes are available for the CellMirror?
What is the curvature range for the CellMirror?
What is the main function of the CellMirror?
How long has CRYSTECH been manufacturing CellMirrors?
Got more questions? Use the RFQ form to ask the supplier directly.
Similar Products












Need pricing for this product? Send a quick inquiry
Your inquiry has been received.
Create an account by adding a password
Why create an account?
- Auto-complete inquiry forms
- View and manage all your past messages
- Save products to your favorites
- Close your account anytime — no hassle